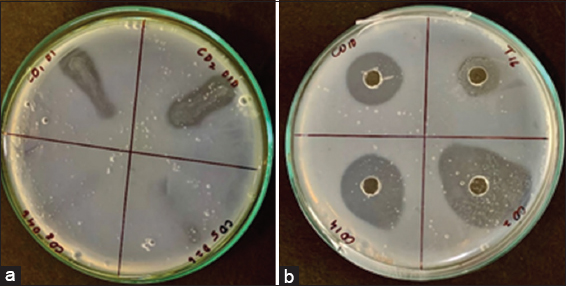

ARTICLE HIGHLIGHTS
Globally, cardiovascular illnesses are the major cause of mortality. Microbial fibrinolytic enzymes have drawn a lot more interest recently due to the high price and side effects of conventional thrombolytic drugs. There are both microbial and non-microbial sources of fibrinolytic enzymes. Earthworms, edible mushrooms, and snake venom are examples of non-microbial sources. When it comes to microbial sources, fibrinolytic enzymes have been found in a variety of bacteria, fungi, and actinomycetes, with the Bacillus species standing out as the most prominent. There are many studies reporting the fibrinolytic enzymes from fermented foods such as tempeh, douchi, Korean salt-fermented anchovy-jet, and shiokara. This study was done to find out fibrinolytic enzyme producers from non-food sources such as mangrove soils which are one of the most productive forms of ecosystem. To the best of our knowledge, this is the first report on the isolation of fibrinolytic enzymes-producing strains from Coringa mangroves. Here for the 1st time, we are reporting the isolation, screening, and characterization of an isolate AIBL_AMSB2 from Coringa mangrove identified as Bacillus subtilis subsp. Inaquosorum for its fibrinolytic activity. Further study also reported an increase in enzyme activity by mutagenesis and production of the enzyme by fermentation reporting the highest protease activity from B. subtilis among the non-food sources.
1. INTRODUCTION
Cardiovascular diseases (CVDs) present an increasing public health concern, especially for people with hypertension, myocardial infarction, coronary heart disease, or stenocardia. The WHO has predicted that by 2030, CVDs will remain the leading cause of death, affecting approximately 23.6 million people around the world [1]. Among various types of CVDs, thrombosis is the most commonly occurring lifestyle-related disease. Fibrinolytic enzymes are therapeutic enzymes used for the treatment of thrombosis. Fibrinolytic enzymes help in removing the thrombus or clots resulting from fibrinogen through activated thrombin. The unhydrolyzed clots result in thrombosis under unstable conditions such as myocardial infarction or hypertension [2]. To date, fibrinolytic enzymes are the most effective drugs for treating thrombosis. Based on their mode of action, they are categorized into two types: (i) those that can lyse the fibrin directly termed as a plasmin-like fibrinolytic enzyme, and (ii) plasminogen activators (PAs) that lyse fibrin by the formation of plasmin from plasminogen, for example, tissue PA, streptokinase, and urokinase. Given the high cost and low specificity of PAs leading to internal hemorrhage once administered for thrombolytic therapy caused due to fibrinolytic enzymes from animal sources, there exists a dire need to find safe and cost-effective alternatives, microbial fibrinolytic enzymes are being touted as promising new alternative option in this context [1,3].
Since microbes are capable of producing value-added products in a cost-effective manner, scientists are exploring this route to produce the fibrinolytic enzyme to make it affordable for the masses. Microbes are known to produce these fibrinolytic enzymes since ancient times, and several fibrinolytic enzymes have been identified from these microbial resources, especially Bacillus sp. during the past few decades from fermented food sources. Apart from Bacillus species, several filamentous fungi such as Mucor, Fusarium oxysporum, Rhizopus chinensis, Cordyceps militaris, Armillaria mellea have also been reported to produce fibrinolytic proteases [1-7]. However, most of these isolates were obtained from traditional food sources and therefore, other biodiversity-rich sources should also be explored with the possibility of finding out better producers of fibrinolytic enzymes.
Marine sediments are rich in biodiversity, especially mangroves are economically and ecologically the most productive form of marine systems. They are rich in nutrients and thus offer a good niche for a diverse class of microbes. Therefore, these are considered reservoirs for various ecologically important microbial communities that play important roles in biogeochemical processes and are rich in bioactive metabolites and enzymes [8,9]. Coringa mangroves are one such mangrove region in India, situated in Coringa Wildlife Sanctuary, Kakinada District, Andhra Pradesh. Since the samples from this region have not been extensively explored previously, we decided to carry out the present work with an aim to screen and isolate novel microbes with fibrinolytic enzyme production potential.
Hence, the main objective of the work was to isolate potent fibrinolytic enzyme-producing microorganisms from samples obtained from the mangrove soil of Coringa Wildlife Sanctuary. In this study, we have screened, isolated, and characterized a fibrinolytic enzyme-producing strain from mangrove soil sediments. The isolated strain was further subjected to physical ultra-violet (UV) and chemical mutagenesis ethyl methyl sulfonate (EMS) to improve its fibrinolytic activity. Finally, batch fermentation was carried out to evaluate the developed strain in tightly controlled experimental conditions.
2. MATERIALS AND METHODS
2.1. Chemicals
All the chemicals and media components used in the present work were purchased from HiMedia Laboratories Pvt Ltd. (Mumbai) unless otherwise mentioned. Solvents used in this study were purchased from Merck. Fibrinogen was purchased from Sigma Aldrich, USA. Agarose was purchased from Lonza Rockland, ME, USA. Hammarsten Grade Casein was purchased from MP Biochemicals, India. Trichloroacetic acid was purchased from Fisher Scientific, USA.
2.2. Collection and Processing of Mangrove Soil Sample
Approximately, 1 kg of soil was collected from mangroves at Coringa Wildlife Sanctuary, Kakinada District, Andhra Pradesh (Latitude 16°49’18.5”N 82°17’53.2”E Longitude 16.821803, 82.298114). The samples were collected, labeled, and transported to the laboratory in sterile polythene zip lock bags and stored in the cold room at 4°C for further studies. A total of 30 sampling sites were chosen based on different plant species. The soil was collected from a depth of 10 cm (the top 3 cm was removed) using a sterile auger and spade. All the samples were transported to the laboratory, shade-dried, and mixed thoroughly before beginning the experiment. Samples were stored at 4°C for further analysis (Panasonic NR-BX468V).
2.3. Screening for Proteolytic Activity
Primary screening was done to isolate the protease producers following the standard method. All 30 mangrove soil samples were initially screened for microbes exhibiting proteolytic activity. For this, 1 g of each thoroughly mixed mangrove soil sample was serially diluted (10-1–10-6) and plated on the skimmed milk agar (SMA) containing (w/v) 0.6% tryptone, 0.2% yeast extract, 1% dextrose, 2% skimmed milk, and 2% agar. This was followed by incubation of plates at 37°C for 24 h (Lab matrix) [10]. Colonies showing the largest zone of clearance on the skimmed milk plate were further analyzed for protease production in submerged fermentation using skimmed milk broth (SMB). After completion of the incubation period, 10 mL of culture broth was centrifuged (10,000 rpm, 10 min, 4°C) (Remi C24-plus) and the supernatant was used for the evaluation of total protein content and protease activity.
2.4. Screening for Fibrinolytic Potential
The most promising primary isolates (12 numbers) obtained during the screening of proteolytic activity were further evaluated for fibrinolytic potential. For this, the isolates were streaked on modified fibrin agar (MFA) plates containing 0.6% w/v human fibrinogen in 0.2M Tris-HCl buffer (pH 7.2), which was mixed with 0.1 mL of 10 NIH Units/mL of human thrombin. The plates were placed at room temperature for 1 h for the formation of the fibrin clot. Later, the plates were incubated for 24 h at 37°C in an incubator. The appearance of the zone of clearance on the fibrin agar plate indicated the fibrinolytic potential of tested isolates [11]. Isolates showing maximum fibrinolytic activity were selected, further analyzed by fibrin assay, purified, and stored for further use.
2.5. Characterization of Isolated Fibrinolytic Bacteria
2.5.1. Carbohydrate utilization test
Initially, the isolated strain AIBL_AMSB2 was characterized by Gram staining using Gram’s staining kit (HiMedia, Cat no: K001-1 KT) as well as biochemical and carbohydrate utilization tests using KB009 HiCarbohydrate™ and KB002 HiAssorted™ Biochemical test kit supplied by HiMedia, Mumbai, India.
2.5.2. β-hemolysis test
β-hemolysis activity was evaluated on 5% of sheep blood agar plates (HiMedia). 24-h-old isolate from nutrient agar was streaked on the blood agar plate and incubated at 37°C overnight. After incubation, the presence of a zone of clearance around the colony is an indication of β-hemolysis activity [12].
2.5.3. Gelatinase test
To check the gelatinase activity nutrient gelatine agar containing 0.5% peptone, 0.5% NaCl, 0.15% HM peptone B, 0.15% yeast extract, 3% gelatine, and 2% agar was prepared. 2 μL of fresh inoculum was added at the center of the nutrient gelatine agar plate and incubated for 48 h at 37°C to observe the appearance of a zone of clearance [13].
2.5.4. Starch hydrolysis test
Modified starch agar comprising 1% soluble starch, 2% peptone, 0.2% (NH4) SO4, 0.1% KH2PO4, 0.001% MgCl2, 0.001% FeSO4.7H2O, and 2% agar was prepared as per [14]. The isolate was streaked on the agar and incubated for 48 h at 37°C. After incubation, the plate was flooded with Gram’s iodine solution and observed for the zone of hydrolysis around the isolate.
2.5.5. Catalase test
Catalase activity was evaluated following the method described by Iwase et al., (2013) [15]. For this, 1 mL of 30% H2O2 was added to the 24-h-old culture grown on Nutrient Agar and smeared on a clean slide. The instant occurrence of effervescence indicates a catalase-positive organism.
2.5.6. Molecular Identification
Using the 16S rRNA-F and 16S rRNA-R primers from the BDT v3.1 Cycle sequencing kit and the ABI 3730xl Genetic Analyzer, the 16S rRNA gene was amplified. Aligner software was used to create a 16S rRNA gene consensus sequence from forward and reverse sequencing data. The NCBI GenBank database’s “nr” database was searched using the 16S rRNA gene sequence. The first 10 sequences were chosen and aligned using Clustal W multiple alignment software based on the maximum identity score. Using MEGA 10, a distance matrix and phylogenetic tree were created [16,17]. This work was done at Barcode Biosciences, Bangalore.
2.6. Analytical Methods
2.6.1. Protease assay
The crude enzyme was mixed with potassium phosphate buffer (0.25 mL, 50 mM, and pH 7.5) and 1.25 mL of 0.6% casein solution, followed by incubation at 37°C for 15 min. After 15 min, the reaction was terminated by adding 1.25 mL of 110 mM Trichloroacetic acid and incubating the reaction mixture at room temperature for 30 min. Finally, the absorbance of the sample was measured at 280 nm against blank. One unit of enzyme activity is defined as the amount of tyrosine (μg) released per min per mL at 37°C [18]. The total protein content was determined by Bradford’s method [19].
2.6.2. Fibrinolytic activity assay
For this, 0.1 mL of supernatant containing crude enzyme was mixed with 2.5 mL of Tris-HCl buffer (0.1M, pH 7.8) containing calcium chloride (0.01 M). To this mixture, 2.5 mL of fibrin (1% w/v) was added. The reaction mixture was incubated at 37°C for 30 min(s), after which the reaction was stopped by the addition of 5 mL of trichloroacetic acid (0.11 M) containing sodium acetate (0.22 M) and acetic acid (0.33 M). Finally, the absorbance of this sample was measured at 275 nm against a blank following the method used by Vijayaraghavan et al., (2019) [20].
2.6.3. Biomass determination
The growth of bacterial isolates was estimated by measuring the optical density at 600 nm (OD600) in a UV-Vis spectrophotometer (Shimadzu).
2.7. Strain Improvement
2.7.1. Physical mutagenesis by UV irradiation
Physical mutagenesis was performed using UV radiations. For this, initially, 4 mL of the bacterial culture (OD600 = 1) was pipetted out into a sterile flat-bottom petri dish (80 mm). This was followed by exposure of cells to UV from a distance of 30 cm using a UV lamp (30 W) in the Laminar airflow chamber (Bio base). Cells were exposed for 30, 60, and 90 min to UV light. Exposed cultures were initially incubated at 37°C for 6 h. After 6 h, 1 mL of the inoculum was serially diluted and plated onto SMA medium and the plates were kept for incubation at 37°C. After 24 h incubation, mutants showing improved enzyme activity (measured by the diameter of the zone of clearance) were selected for total protein content and protease activity. The mutant showing the highest total protein content, protease activity, and fibrinolytic activity was chosen for chemical mutagenesis [21,22].
2.7.2. Chemical mutagenesis by EMS
EMS was used for the chemical mutagenesis of UV mutants. Different concentrations of EMS (5 μg/mL, 10 μg/mL, 25 μg/mL, 50 μg/mL, and 100 μg/mL) were added to an overnight culture of the isolate (OD600 = 1). The cell suspension was incubated for a time interval of −30, −60, −90, and −120 min(s). After the incubation time was over, the cells were centrifuged and washed thrice with saline. Later, 1 mL of the suspension was serially diluted up to 10-6 dilutions and plated onto SMA plates. Mutants showing larger zone of clearance on skim milk plates were counted and evaluated for total protein content and protease activity. The mutant showing the highest total protein content along with protease and fibrinolytic activity was chosen for further studies [23,24].
2.8. Fermentation Conditions
For fermentation studies, culture was grown on SMB media containing – 0.2% skimmed milk, 0.6% tryptone, 0.3% yeast extract, and 0.1% dextrose. The fermentation run was carried out in a 5 L fermenter (Fermex, India) with a 2.5 L working volume. Media was inoculated with 1% of culture grown for approximately 14 h (OD600 = 1) and a fermentation run was carried out for 16 h at 37°C and 150 rpm. Dissolved oxygen concentration was maintained at 20% of saturated air.
2.9. Statistical Analysis
The Duncan Multiple Range Test was used with One-way analysis of variance in IBM SPSS Statistics version 24.0. The data were shown as means SE (variable) with a statistical difference of P < 0.05.
3. RESULTS AND DISCUSSION
3.1. Isolation and Screening for Fibrinolytic Enzyme Producer
3.1.1. Primary screening for potential protease producer
Mangroves have been a source of various proteolytic enzymes including proteases. Mangrove soils create a rich habitat for the growth of various microorganisms and a wide interaction between the microbial communities in mangrove soils results in the production of a wide range of secondary metabolites. Earlier, Coringa mangroves have been studied for their seasonal impacts on the nutrient composition of soils [25]. In the present study, a total of 30 soil samples were collected from Coringa mangroves. Screening of collected soil samples resulted in the isolation of a total of 200 bacterial isolates showing a zone of clearance on SMA plates. Given the substantially large number of isolates obtained during primary screening on the SMA plate, 61 isolates were selected for the next round of screening based on their relative size of the zone of clearance on the SMA plate. These handpicked 61 protease-positive isolates obtained during primary screening were further tested quantitatively (secondary screening) for their protease-producing potential in SMB. Cell-free supernatant collected through centrifugation served as a crude sample for quantitative evaluation of protease activity. Based on the results of secondary screening, finally, 12 isolates, namely – CO1-001, CO2-010, CO5-026, CO8-046, CO10-057, CO11-064, CO13-080, CO14-085, CO15-091, CO16-101, CO18-127, and CO23-155 were selected for further studies [Figure 1]. These 12 isolates were designated as the most promising primary isolates. Similarly, extracellular protease producer Vibrio fluvialis VM 10 was isolated from the sediment sample taken from a mangrove station in the Cochin estuary [26]. In another study, Bacillus circulans BM15 was also isolated from mangrove samples and was evaluated for its capabilities to produce detergent enzymes [27]. Mangrove samples from Thuwal, a coastal location in Jeddah, Saudi Arabia have been used to isolate hydrolytic enzyme-producing bacteria which were further investigated for antifungal properties as well [28]. Similarly, an alkaline protease producing Solibacillus silvestris exhibiting a maximum of 258.75 U/mL alkaline protease activity, has also been reported from the Gir mangrove region in India [29].
 | Figure 1: Total protein content and protease activity (u) of the 12 isolates (CO1-001, CO2-010, CO5-026, CO8-046, CO10-057, CO11-064, CO13-080, CO14-085, CO15-091, CO16-101, CO18-127, and CO23-155) screened from Coringa mangroves soil samples. The values indicate the mean ± SE of three replicates. [Click here to view] |
3.1.2. Secondary screening for potential isolates with fibrinolytic enzyme producer
In the next stage, secondary screening of isolates positive for protease production was done to evaluate their fibrinolytic potential. All the selected 12 primary isolates were tested for their fibrinolytic activity on the MFA plate (plate assay) and four of these strains, namely – CO1-01, CO2-10, CO10-57, and CO18-127 were found to be positive for fibrinolytic activity, indicated by the presence of a zone of clearance on the fibrin agar plate. Among the positive strains for fibrinolytic potential, CO2-10 showed the highest activity with the largest zone of clearance (0.48 ± 0.03 cm) on MFA plates [Figures 2a and b]. Similarly, while evaluating these strains quantitatively by fibrin assay, CO2-10 was found to exhibit the highest fibrinolytic activity (69.13 ± 3.62 mg/mL) and was finally designated the name AIBL_AMSB2 [Figure 3]. Fermented foods have been a major source of fibrinolytic enzymes have been reported wherein screening and isolation of the Bacillus amyloliquefaciens strain KJ10, capable of producing fibrinolytic enzymes from fermented soybeans [30]. Similarly, fibrinolytic enzymes-producing Bacillus subtilis LD-8547 have also been isolated from fermented food products like douchi [31]. B. subtilis HK176 was obtained from fermented food, namely Cheonggukjang [32]. Similarly, B. subtilis ZA400, from a Korean fermented food known as kimchi [33]. B. amyloliquefaciens MCC2606 isolated from dosa batter, an Indian fermented food [34]. B. amyloliquefaciens RSB34 isolated from doenjang, a traditional fermented Korean soy-based food [35]. Gembus, a fermented soybean cake from Indonesia, is the source of Bacillus pumilus, which has been found to secrete a number of protease enzymes with potent fibrinolytic properties [36]. Another bacterium (TP-6) producing fibrinolytic enzyme from a fermented soybean dish called Tempeh was isolated and identified as B. subtilis [37]. One Staphylococcus sp. producing a new fibrinolytic enzyme (AJ) has also been isolated from Korean salt-fermented anchovy-jet [38]. Similarly, a novel fibrinolytic enzyme called katsuwokinase was earlier discovered in skipjack “Shiokara,” a classic salt-fermented delicacy from Japan. Skipjack Shiokara (Katsuwonus pelamis) crude enzyme has been reported to have extremely potent fibrinolytic activity [39]. Although there are many reports on the isolation of microbes with fibrinolytic potential from food sources, there are very few reports on screening and isolation of fibrinolytic enzymes from non-food sources except a few reports from soil sources [40-44]. To the best of our knowledge, there are no reports on the isolation of organisms with fibrinolytic potential from the mangrove soil sediments.
| Figure 2: (a) Isolate CO2-010 isolated from Coringa soil, streaked on fibrin agar plates for evaluation of Fibrinolytic activity (b) Enzyme supernatant of CO2-010 obtained after centrifugation of the skim milk broth inoculated with, isolate CO2-010 after 24 h incubation showing fibrinolytic activity on fibrin agar plates. The zone of clearance indicates the presence of the fibrinolytic enzyme. [Click here to view] |
 | Figure 3: Fibrin activity (mg/mL) of isolates CO1-001, CO2-010, CO10-057, CO11-064, CO13-080, CO14-085, CO18-127, and CO23-155 after 24 h(s) incubation determined by fibrin assay. The values indicate the mean ± SE of three replicates. [Click here to view] |
3.2. Characterization of Isolated Strain with Fibrinolytic Potential
The isolated AIBL_AMSB2 was maintained as a pure culture on the nutrient agar plate. Initially, AIBL_AMSB2 was characterized by Gram staining, followed by biochemical tests. Finally, the strain was characterized by 16S rRNA sequencing. The isolate was found to be a Gram-positive rod. It showed b-hemolysis on the blood agar plate indicating the capability of the organism to degrade the blood clots. AIBL_AMSB2 showed negative gelatinase and catalase activity indicating that the isolate AIBL_AMSB2 is a non-virulent strain. In addition to this, the isolate also exhibited amylase activity on the starch agar plate. Out of a total of 12 carbohydrates (lactose, xylose, maltose, fructose, dextrose, galactose raffinose, trehalose, melibiose, sucrose, l-arabinose, and mannose), AIBL_AMSB2 could utilize sugars such as maltose, fructose, dextrose, trehalose, and mannose. The characterization of isolated strains by qualitative test has variously been reported. In one such study, Tariq et al. (2016) have reported the characterization of isolated Bacillus species by various conventional tests starch hydrolysis, casein hydrolysis, gelatin liquefaction, cellulose test, urease test, carbohydrate fermentation, oxidation fermentation, indole test, methyl red, Voges Proskauer, citrate utilization, triple sugar iron, nitrate reduction, catalase, and oxidase [45]. On similar lines, a set of biochemical tests were performed for the identification of the isolates that could degrade crude oil [46]. In the present study, molecular characterization of the isolated strain was also done through 16S rRNA sequencing, and the isolate AIBL_AMSB2 was identified as B. subtilis subsp. Inaquosorum. The sequence was submitted to GenBank with accession number OQ600796. Although other Bacillus species have been found to produce fibrinolytic proteases, like Bacillus natto, B. amyloliqueficans, Bacillus subtilis CK etc, there have only been a limited number of studies with this species of Bacillus i.e., Bacillus inaquosorum, which was isolated from mangrove soil being a non-food source. Earlier, B. inaquosorum-producing fibrinolytic enzymes have been reported from naturally fermented soybean meals from the Eastern Himalayas [47]. Hence, our study is the first such report on the isolation of fibrinolytic enzymes-producing B. inaquosorum, from Coringa mangroves.
3.3. Strain Improvement for Improved Fibrinolytic Potential
3.3.1. Mutagenesis using UV irradiation
UV mutagenesis is an age-old technique to induce favorable mutations in our desired organisms. Mutant strains result in improved and desirable characteristics. By mutagenesis of the native strain and then screening the results, better strains can be produced [48]. In the present study, UV mutagenesis of B. subtilis strain AIBL_AMSB2 was done by exposing the cells to a 30W UV lamp for a time interval of 30–90 min(s). A total of 20 mutants (M1-M20) were obtained after UV mutagenesis. Among these, M7 showed the highest total protein content and protease activity of 95.26 ± 0.83 μg/mL and 217.21 ± 6.14 U followed by M12, M16, and M19, respectively. Under similar experimental conditions, the untreated parent strain (AIBL_AMSB2) showed the highest total protein content and protease activity of 79.33 ± 14 μg/mL and 133.17 ± 1.37 U, respectively [Figure 4]. In the next step, mutants M7, M12, M16, and M19 along with AIBL_AMSB2 (control) were evaluated for their fibrinolytic activity on the MFA plate. Where after, M7 showed the largest zone of clearance (0.96 ± 0.05 cm), followed by M19 (0.89 ± 0.01 cm), M16 (0.80 ± 0.00 cm), control (0.79 ± 0.00 cm), and M12 (0.69 ± 0.01 cm), respectively [Table 1]. Based on this M7 strain (AIBL_AMSB2_M7) was selected for the next round of strain improvement studies using EMS as a chemical mutagen. The use of physical mutagenesis through UV has variously been reported for the hyperproduction of various enzymes. There are many similar reports on the application of UV for the mutation of Bacillus spp. for improved fibrinolytic enzyme production [31,49]. A study reported mutagenesis of vineyard isolated fungal strain which was carried out using UV and nitrosoguanidine to finally develop a hyperpectinase-producing fungal strain. They reported a 9.9% increase in pectinase activity (8363.21–9198.68 U/mL) as a result of mutagenesis [50]. Similarly, mutant Pseudomonas aeruginosa CMSS with two-fold improved nattokinase production capability was obtained by UV-mutagenesis [51]. A recent study mutagenesis by UV-light led to increasing in protease activity by 1.5 times observed in B. subtilis E6 in a study by Demirkan et al. (2018) [52]. Similarly, here, in this study, UV mutagenesis of our B. subtilis strain AIBL_AMSB2 has resulted in approximately 63% increase in overall protease activity after UV mutagenesis with reference to the parent strain (B. subtilis AIBL_AMSB2).
 | Figure 4: Total protein content (μg/mL) and protease activity (u) of the 20 mutants (M1-M20) obtained after UV mutagenesis for 30–90 min(s) from the parent strain AIBL_AMSB2 depicted as control (c). The values indicate the mean ± SE of three replicates. [Click here to view] |
Table 1: Mutants M7, M12, M16, M19, E36, E26, E32, E10 along with AIBL_AMSB2_M7, and parent strain AIBL_AMSB2(C) screened for fibrinolytic activity given in terms of zone of clearance (cm) on the fibrin agar plate. The values indicate the mean±SE (variable) of three replicates.
| S. No | Isolate name | Zone of clearance on fibrin agar (cm) |
|---|---|---|
| 1 | M7 | 0.96±0.03a |
| 2 | M12 | 0.69±0.01d |
| 3 | M16 | 0.80±0.00c |
| 4 | M19 | 0.89±0.01b |
| 5 | E36 | 0.93±0.03c |
| 6 | E26 | 0.69±0.01b |
| 7 | E32 | 1.23±0.03a |
| 8 | E10 | 0.61±0.01e |
| 9 | C | 0.79±0.00c |
3.3.2. Chemical mutagenesis by EMS
Chemical mutagenesis is another way to induce desirable mutations in our organism of choice. There are plenty of reports on combined treatment with physical (UV) and chemical mutagens (EMS) for inducing mutations in microbes, whereby a significant improvement in the desirable properties of mutants has been achieved. In the current study as well, AIBL_AMSB2_M7 obtained after UV mutagenesis for 60 min(s) was further exposed to different concentrations of EMS (−5, −10, −25, −50, and −100 μg/mL) for time intervals in the range of 30–120 min(s). This treatment resulted in 40 mutants (E1-E40), out of which E32 (5 μg/mL EMS treatment for 120 min), exhibited the highest total protein content and protease activity of 253.48 ± 7.00 μg/mL and 253.60 ± 5.41U, respectively, followed by E10 showing 164.34 ± 5.13 μg/mL of total protein content and protease activity of 223.70 ± 21.11 U, E26 showing a protease activity of 217.56 ± 5.28 U and total protein content of 73.48 ± 7.47 μg/mL and E36 showing a 220.91 ± 21.46 μg/mL of total protein content and 213.52 ± 0.13 U of protease activity [Figure 5]. Finally, mutants E36, E26, E32, E10, and M7 based on the protease activity were checked for their fibrinolytic activity on the MFA plate where mutant E32 (AIBL_AMSB2_M7E32) was found to exhibit the largest zone of clearance of 1.2 ± 0.03 cm when compared with UV mutant AIBL_AMSB2_M7 that showed a zone of clearance of 0.96 ± 0.05 cm and untreated control showing 0.79 ± 0.00 cm zone of clearance [Table 1]. Thus, resulting in a 54.07% increases in fibrinolytic activity after EMS mutagenesis. Therefore, EMS-treated strain resulted in improved protease activity and fibrinolytic activity, and the comparative results are been shown in [Table 2]. Similarly, Demirkar and Ozdemir (2020) have also used EMS to get an improved B. subtilis E6-5 strain, where protease production in the mutant strain was improved by 9.2 folds as compared to the original strain [53]. In another study, Serratia marcescens was repeatedly exposed to UV light and EMS, either separately or in combination, to produce a mutant with increased serrapeptase activity. The enzyme activity increased to 3437.6 EU/mL from 2770 EU/mL [21]. Apart from the fibrinolytic enzyme production, UV and EMS combined effects have also been reported in various other applications [54-56] and are considered to be a time-tested technique to develop improved mutants reported in the present study.
 | Figure 5: Total protein content (μg/mL) and protease activity (u) of the 40 mutants (E1-E40) obtained after EMS mutagenesis from the UV mutant strain AIBL_AMSB2_M7 and parent strain AIBL_AMSB2 depicted as control (c). The values indicate the mean ± SE of three replicates. [Click here to view] |
Table 2: A comparison of total protein content (μg/mL), Protease activity (U) and Fibrinolytic activity (cm) of parent (AIBL_AMSB2) and mutant isolates (AIBL_AMSB2_M7) and (AIBL_AMSB2_M7E32) from Coringa mangrove soil. The values indicate the mean±SE (variable) of three replicates.
| Isolate name (Bacillus subtilis) | Total protein content (mg/mL) | Protease activity (U) | Fibrinolytic activity (cm) |
|---|---|---|---|
| Parent (AIBL_AMSB2) | 143.14±0.33bcd | 147.72±2.26bcd | 0.79±0.00c |
| UV mutant (AIBL_AMSB2_M7) | 190.53±0.83a | 217.21±6.14a | 0.96±0.03a |
| UV and EMS mutant (AIBL_AMSB2_M7E32) | 253.48±7.00a | 253.60±5.41a | 1.23±0.03a |
Using IBM SPSS software, ver.24, Duncans Multiple range test shows that the mean value with similar alphabets are not statistically different at p≤0.05.
3.4. Fermenter Scale Study for Fibrinolytic Enzyme Production Using Improved Strain
Many studies have proved that the most favored approach for producing fibrinolytic enzymes is through submerged fermentation in tightly controlled experimental conditions [57-59]. During our shake flask studies using mutant strain AIBL_AMSB2_M7E32, the pH of the media was found to increase up to 8.5, and therefore, it was decided to evaluate the capabilities of the developed mutant strain in tightly controlled environmental conditions. Shake flask studies with AIBL_AMSB2_M7E32 resulted in a maximum of 4.65 OD600 whereas total protein content and maximum protease activity were found to be 73 ± 1.00 mg/mL and 70 ± 1.12 U, respectively. Following this, a batch fermentation run was carried out for 16 h under similar experimental conditions. During this run, the total protein and fibrinolytic activity of the fermentation broth started decreasing after 12 h of the fermentation run. This might be due to the exhaustion of fermentable sugar in culture media, which came down to approximately 2 g/L within 8 h of the fermentation run. Although, some cell growth was observed till 16 h of fermentation run. During this study, a maximum of 10.86 OD600 could be achieved after 12 h of growth, which is 2.3-fold, i.e., 133.54% higher than the biomass obtained during the flask study under similar experimental conditions correlating with dry cell weight of 0.136 g at 8th h of fermentation [Figure 6]. Similarly, total protein content and maximum protease activity were found to be increased by 1.08-fold (79 ± 0.01 μg/mL) and 4.9-fold i.e., 391.11% increase (343 ± 3.11 U), respectively. In addition, fibrinolytic activity was also increased by 1.3-fold during the fermenter study [Figure 7]. Similar to this, there is plenty of literature showing the efficacy of controlled environmental conditions during fermentation runs resulting in improved performance with respect to fibrinolytic enzyme production. In one such study, a 2.6-fold increase in nattokinase production was observed in an un-optimized medium during submerged fermentation [60].
 | Figure 6: Growth profile, dry cell weight profile of Bacillus subtilis AIBL_AMSB2_M7 during the course of a 16 h(s) fermentation in a 5 L In situ fermenter under controlled conditions. The values indicate the mean ± SE of three replicates. [Click here to view] |
 | Figure 7: Protein profile, protease activity, and fibrinolytic activity profiles of Bacillus subtilis AIBL_AMSB2_M7 during the course of a 16 h(s) fermentation in a 5 L in situ fermenter under controlled conditions. The values indicate the mean ± SE of three replicates. [Click here to view] |
4. CONCLUSION
CVDs are the leading cause of death across the globe. Due to the high costs and adverse effects of traditional thrombolytic medicines, microbial fibrinolytic enzymes have gotten a lot more attention. Enzymes are a modest but valuable segment of the therapeutic protein industry. Fibrinolytic enzymes are derived from microbial and non-microbial sources. Non-microbial sources include snake venom, earthworms, and edible mushrooms. In the case of microbial sources, fibrinolytic enzymes have been identified in various bacteria, fungi, and actinomycetes among which the most notable is the Bacillus genus. Mangrove soils create a rich habitat for the growth of various microorganisms. A wide interaction between the microbial communities in mangrove soils results in the production of various secondary metabolites. The search for these metabolites in mangrove soils is challenging as the soils are highly saline, moist, and alkaline. To the best of our knowledge, no isolates producing fibrinolytic enzymes from Coringa mangroves have been reported till date. In this study, for the first time we are reporting the isolation, screening, and characterization of an isolate AIBL_AMSB2 from the Coringa mangrove. The isolated strain was identified as B. subtilis subsp. Inaquosorum. Isolated strain was improved for its fibrinolytic potential by physical and chemical mutagenesis, resulting in 1.73-fold increase in fibrinolytic activity. Likewise, an increase of 4.9-fold in enzyme activity was observed in fermenter-scale enzyme production. Since this study was performed in un-optimized conditions, we anticipate further improvement in fibrinolytic enzyme production by medium optimization, process optimization, and application of advanced fermentation strategies such as fed-batch, high cell density cultivation, and cell cultivation with in situ product recovery. Given the fast growth cycle of developed strain, it offers high productivity and could be considered a suitable candidate for the development of a commercially viable process for fibrinolytic enzyme production at an industrial scale.
5. ACKNOWLEDGMENT
The authors are indebted to the Department of Life Sciences, CHRIST (Deemed to be University) for providing laboratory facilities and Barcode Biosciences for molecular identification. The authors would like to extend their gratitude to Kondapalli Vamsi Krishna and Koushik Koujalagi for their support during fermentation Batches. The author Sompalli Bhavana is extremely grateful to the Department of Science and Technology, KSTePS, Government of Karnataka for providing fellowship.
6. AUTHOR CONTRIBUTION
Sompalli Bhavana has participated in the concept and research design, data collection, data analysis, interpretation of results, and writing the manuscript. Dr. Alok Malaviya contributed to the idea and design of the experimental work along with a major revision of the article. The manuscript has been approved by both authors.
7. CONFLICTS OF INTEREST
The authors report no financial or any other conflicts of interest in this work.
8. ETHICAL APPROVAL
This study does not involve experiments on animals or human subjects.
9. DATA AVAILABILITY
All the data is available with the authors and shall be provided upon request.
10. PUBLISHER’S NOTE
This journal remains neutral with regard to jurisdictional claims in published institutional affiliation.
REFERENCES
1. Hu Y, Yu D, Wang Z, Hou J, Tyagi R, Liang Y, et al. Purification and characterization of a novel, highly potent fibrinolytic enzyme from Bacillus subtilisDC27 screened from Douchi, a traditional Chinese fermented soybean food. Sci Rep 2019;9:9235. [https://doi.org/10.1038/s41598-019-45686-y]
2. Kotb E. The biotechnological potential of fibrinolytic enzymes in the dissolution of endogenous blood thrombi. Biotechnol Prog 2014;30:656-72. [https://doi.org/10.1002/btpr.1918]
3. Duffy MJ. Urokinase plasminogen activator and its inhibitor, PAI-1, as prognostic markers in breast cancer:From pilot to level 1 evidence studies. Clin Chem 2002;48:1194-7. [https://doi.org/10.1093/clinchem/48.8.1194]
4. Urano T, Ihara H, Umemura K, Suzuki Y, Oike M, Akita S, et al. The profibrinolytic enzyme subtilisin NAT purified from Bacillus subtiliscleaves and inactivates plasminogen activator inhibitor Type 1. J Biol Chem 2001;276:24690-6. [https://doi.org/10.1074/jbc.M101751200]
5. Peng Y, Huang Q, Zhang RH, Zhang YZ. Purification and characterization of a fibrinolytic enzyme produced by Bacillus amyloliquefaciens DC-4 screened from douchi, a traditional Chinese soybean food. Comp Biochem Physiol B Biochem Mol Biol 2003;134:45-52. [https://doi.org/10.1016/S1096-4959(02)00183-5]
6. Wei X, Luo M, Xu L, Zhang Y, Lin X, Kong P, et al. Production of fibrinolytic enzyme from Bacillus amyloliquefaciens by fermentation of chickpeas, with the evaluation of the anticoagulant and antioxidant properties of chickpeas. J Agric Food Chem 2011;59:3957-63. [https://doi.org/10.1021/jf1049535]
7. Chang CT, Wang PM, Hung YF, Chung YC. Purification and biochemical properties of a fibrinolytic enzyme from Bacillus subtilis-fermented red bean. Food Chem 2012;133:1611-7. [https://doi.org/10.1016/j.foodchem.2012.02.061]
8. Zhang L, Niaz SI, Khan D, Wang Z, Zhu Y, Zhou H, et al. Induction of diverse bioactive secondary metabolites from the mangrove endophytic fungus Trichoderma sp. (strain 307) by co-cultivation with Acinetobacter johnsonii (strain B2). Mar Drugs 2017;15:35. [https://doi.org/10.3390/md15020035]
9. Vinoth R, Kumaravel S, Ranganathan R. Therapeutic and traditional uses of mangrove plants. J Drug Deliv Ther 2019;9:849-54. [https://doi.org/10.22270/jddt.v9i4-s.3457]
10. Yazid NA, Barrena R, Sánchez A. Assessment of protease activity in hydrolysed extracts from SSF of hair waste by and indigenous consortium of microorganisms. Waste Manag 2016;49:420-6. [https://doi.org/10.1016/j.wasman.2016.01.045]
11. Agrebi R, Haddar A, Hajji M, Frikha F, Manni L, Jellouli K, et al. Fibrinolytic enzymes from a newly isolated marine bacterium Bacillus subtilisA26:Characterization and statistical media optimization. Can J Microbiol 2009;55:1049-61. [https://doi.org/10.1139/W09-057]
12. Semedo T, Santos MA, Lopes MF, Marques JJ, Crespo MT, Tenreiro R. Virulence factors in food, clinical and reference enterococci:A common trait in the genus?Syst Appl Microbiol 2003;26:13-22. [https://doi.org/10.1078/072320203322337263]
13. Botes M, van Reenen CA, Dicks LM. Evaluation of Enterococcus mundtii ST4SA and Lactobacillus plantarum 423 as probiotics by using a gastro-intestinal model with infant milk formulations as substrate. Int J Food Microbiol 2008;128:362-70. [https://doi.org/10.1016/j.ijfoodmicro.2008.09.016]
14. Luang-In V, Yotchaisarn M, Saengha W, Udomwong P, Deeseenthum S, Maneewan K. Isolation and identification of amylase-producing bacteria from soil in Nasinuan community forest, Maha Sarakham, Thailand. Biomed Pharmacol J 2019;12:1061-8. [https://doi.org/10.13005/bpj/1678 https://doi.org/10.13005/bpj/1735]
15. Iwase T, Tajima A, Sugimoto S, Okuda KI, Hironaka I, Kamata Y, et al. Asimple assay for measuring catalase activity:A visual approach. Sci Rep 2013;3:3081. [https://doi.org/10.1038/srep03081]
16. Kumar S, Stecher G, Tamura K. MEGA7:Molecular evolutionary genetics analysis version 7.0 for bigger datasets. Mol Biol Evol 2016;33:1870-4. [https://doi.org/10.1093/molbev/msw054]
17. Kimura M. A simple method for estimating evolutionary rates of base substitutions through comparative studies of nucleotide sequences. J Mol Evol 1980;16:111-20. [https://doi.org/10.1007/BF01731581]
18. Cupp-Enyard C. Sigma's non-specific protease activity assay-casein as a substrate. J Vis Exp 2008;19:899. [https://doi.org/10.3791/899-v]
19. Bradford MM. A rapid and sensitive method for the quantitation of microgram quantities of protein utilizing the principle of protein-dye binding. Anal Biochem 1976;72:248-54. [https://doi.org/10.1016/0003-2697(76)90527-3]
20. Vijayaraghavan P, Arasu MV, Rajan RA, Al-Dhabi NA. Enhanced production of fibrinolytic enzyme by a new Xanthomonas oryzae IND3 using low-cost culture medium by response surface methodology. Saudi J Biol Sci 2019;26:217-24. [https://doi.org/10.1016/j.sjbs.2018.08.029]
21. Gopinath S, Venkataprasad R, Rajnish KN, Datta S, Selvarajan E. Enhancement of serrapeptase hyper producing mutant by combined chemical and UV mutagenesis and its potential for fibrinolytic activity. J Pure Appl Microbiol 2020;14:1295-303. [https://doi.org/10.22207/JPAM.14.2.25]
22. Ghosal T, Augustine N, Siddapur A, Babu V, Samuel MK, Chandrasekaran SD. Strain improvement, optimization and purification studies for enhanced production of streptokinase from Streptococcus uberis TNA-M1. Front Biol 2017;12:376-84. [https://doi.org/10.1007/s11515-017-1467-x]
23. Talebi AB, Talebi AB, Shahrokhifar B. Ethyl methane sulphonate (EMS) induced mutagenesis in Malaysian rice (cv. MR219) for lethal dose. Am J Plant Sci 2012;3:1661-5. [https://doi.org/10.4236/ajps.2012.312202]
24. Asia L, Mohsin I, Muhammad A. Ethyl methane sulfonate chemical mutagenesis of Bacillus subtilisfor enhanced production of protease. Org Med Chem Int J 2018;5:555664. [https://doi.org/10.19080/OMCIJ.2018.05.555664]
25. Rao K, Priya N, Ramanathan AL. Impact of seasonality on the nutrient concentrations in Gautami-Godavari estuarine mangrove complex, Andhra Pradesh, India. Mar Pollut Bull 2018;129:329-35. [https://doi.org/10.1016/j.marpolbul.2018.02.052]
26. Venugopal M, Saramma AV. Characterization of alkaline protease from Vibrio fluvialis strain VM10 isolated from a mangrove sediment sample and its application as a laundry detergent additive. Process Biochem 2006;41:1239-43. [https://doi.org/10.1016/j.procbio.2005.12.025]
27. Venugopal M, Saramma AV. An alkaline protease from Bacillus circulans BM15, newly isolated from a mangrove station:Characterization and application in laundry detergent formulations. Indian J Microbiol 2007;47:298-303. [https://doi.org/10.1007/s12088-007-0055-1]
28. Bibi F, Ullah I, Alvi SA, Bakhsh SA, Yasir M, Al-Ghamdi AA, et al. Isolation, diversity, and biotechnological potential of rhizo- and endophytic bacteria associated with mangrove plants from Saudi Arabia. Genet Mol Res 2017;16. [https://doi.org/10.4238/gmr16029657]
29. Kharadi A, Chaudhary K, Patel F. Optimization of alkaline protease production by Solibacillus silvestris, isolated from Gir region of Gujarat. Indian J Sci Technol 2020;13:1065-77. [https://doi.org/10.17485/ijst/2020/v013i09/149812]
30. Rajaselvam J, Benit N, Alotaibi SS, Rathi MA, Srigopalram S, Biji GD, et al. In vitro fibrinolytic activity of an enzyme purified from Bacillus amyloliquefaciens strain KJ10 isolated from soybean paste. Saudi J Biol Sci 2021;28:4117-23. [https://doi.org/10.1016/j.sjbs.2021.04.061]
31. Wang SH, Zhang C, Yang YL, Diao M, Bai MF. Screening of a high fibrinolytic enzyme producing strain and characterization of the fibrinolytic enzyme produced from Bacillus subtilisLD-8547. World J Microbiol Biotechnol 2008;24:475-82. [https://doi.org/10.1007/s11274-007-9496-2]
32. Jeong SJ, Heo K, Park JY, Lee KW, Park JY, Joo SH, et al. Characterization of AprE176, a fibrinolytic enzyme from Bacillus subtilisHK176. J Microbiol Biotechnol 2015;25:89-97. [https://doi.org/10.4014/jmb.1409.09087]
33. Ahn MJ, Ku HJ, Lee SH, Lee JH. Characterization of a novel fibrinolytic enzyme, BsfA, from Bacillus subtilisZA400 in Kimchi reveals its pertinence to thrombosis treatment. J Microbiol Biotechnol 2015;25:2090-9. [https://doi.org/10.4014/jmb.1509.09048]
34. Devaraj Y, Rajender SK, Halami PM. Purification and characterization of fibrinolytic protease from Bacillus amyloliquefaciens MCC2606 and analysis of fibrin degradation product by MS/MS. Prep Biochem Biotechnol 2018;48:172-80. [https://doi.org/10.1080/10826068.2017.1421964]
35. Yao Z, Liu X, Shim JM, Lee KW, Kim HJ, Kim JH. Properties of a fibrinolytic enzyme secreted by Bacillus amyloliquefaciens RSB34, isolated from Doenjang. J Microbiol Biotechnol 2017;27:9-18. [https://doi.org/10.4014/jmb.1608.08034]
36. Afifah DN, Sulchan M, Syah D, Yanti, Suhartono MT, Kim JH. Purification and Characterization of a fibrinolytic enzyme from Bacillus pumilus 2.g isolated from Gembus, an Indonesian fermented food. Prev Nutr Food Sci 2014;19:213-9. [https://doi.org/10.3746/pnf.2014.19.3.213]
37. Kim SB, Lee DW, Cheigh CI, Choe EA, Lee SJ, Hong YH, et al. Purification and characterization of a fibrinolytic subtilisin-like protease of Bacillus subtilisTP-6 from an Indonesian fermented soybean, Tempeh. J Ind Microbiol Biotechnol 2006;33:436-44. [https://doi.org/10.1007/s10295-006-0085-4]
38. Choi NS, Song JJ, Chung DM, Kim YJ, Maeng PJ, Kim SH. Purification and characterization of a novel thermoacid-stable fibrinolytic enzyme from Staphylococcus sp. strain AJ isolated from Korean salt-fermented Anchovy-joet. J Ind Microbiol Biotechnol 2009;36:417-26. [https://doi.org/10.1007/s10295-008-0512-9]
39. Sumi H, Nakajima N, Yatagai C. A unique strong fibrinolytic enzyme (katsuwokinase) in skipjack “Shiokara,”a Japanese traditional fermented food. Comp Biochem Physiol B Biochem Mol Biol 1995;112:543-7. [https://doi.org/10.1016/0305-0491(95)00100-X]
40. Albuquerque W, Nascimento T, Brandão-Costa R, Fernandes T, Porto A. Static magnetic field effects on proteases with fibrinolytic activity produced by Mucor subtilissimus. Bioelectromagnetics 2017;38:109-20. [https://doi.org/10.1002/bem.22016]
41. Sharma C, Salem GE, Sharma N, Gautam P, Singh R. Thrombolytic potential of novel thiol-dependent fibrinolytic protease from Bacillus cereus RSA1. Biomolecules 2019;10:3. [https://doi.org/10.3390/biom10010003]
42. Khursade PS, Galande SH, Krishna PS, Prakasham RS. Stenotrophomonas maltophilia Gd2:A potential and novel isolate for fibrinolytic enzyme production. Saudi J Biol Sci 2019;26:1567-75. [https://doi.org/10.1016/j.sjbs.2018.10.014]
43. Xin X, Ambati RR, Cai Z, Lei B. Purification and characterization of fibrinolytic enzyme from a bacterium isolated from soil. 3 Biotech 2018;8:90. [https://doi.org/10.1007/s13205-018-1115-4]
44. Meng D, Dai M, Xu BL, Zhao ZS, Liang X, Wang M, et al. Maturation of fibrinolytic bacillopeptidase F involves both hetero-and autocatalytic processes. Appl Environ Microbiol 2016;82:318-27. [https://doi.org/10.1128/AEM.02673-15]
45. Tariq AL, Sudha S, Reyaz AL. Isolation and screening of Bacillus species from sediments and application in bioremediation. Int J Curr Microbiol Appl Sci 2016;5:916-24. [https://doi.org/10.20546/ijcmas.2016.506.099]
46. Blánquez A, Rodríguez J, Brissos V, Mendes S, Martins LO, Ball AS, et al. Decolorization and detoxification of textile dyes using a versatile Streptomyces laccase-natural mediator system. Saudi J Biol Sci 2019;26:913-20. [https://doi.org/10.1016/j.sjbs.2018.05.020]
47. Kharnaior P, Das M, Tamang JP. Therapeutic and anti-thrombotic properties of some naturally fermented soybean foods of the Eastern Himalayas. Fermentation 2023;9:91. [https://doi.org/10.3390/fermentation9050461 https://doi.org/10.3390/fermentation9020091]
48. Adrio JL, Demain AL. Genetic improvement of processes yielding microbial products. FEMS Microbiol Rev 2006;30:187-214. [https://doi.org/10.1111/j.1574-6976.2005.00009.x]
49. Mohanasrinivasan V, Devi CS, Biswas R, Paul F, Mitra M, Selvarajan E, et al. Enhanced production of nattokinase from UV mutated Bacillus sp. Bangladesh J Pharmacol 2013;8:110-5. [https://doi.org/10.3329/bjp.v8i2.13690]
50. Huang D, Song Y, Liu Y, Qin Y. A new strain of Aspergillus tubingensis for high-activity pectinase production. Braz J Microbiol 2019;50:53-65. [https://doi.org/10.1007/s42770-018-0032-3]
51. Chandrasekaran SD, Vaithilingam M, Shanker R, Kumar S, Thiyur S, Babu V, et al. Exploring the in vitro thrombolytic activity of nattokinase from a new strain Pseudomonas aeruginosa CMSS. Jundishapur J Microbiol 2015;8:e23567. [https://doi.org/10.5812/jjm.23567]
52. Demirkan ES, Sevgi T, Gokoz M, Guler BE, Zeren B, Ozalpar B, et al. Strain improvement by UV mutagenesis for protease overproduction from Bacillus subtilisE6-5 and nutritional optimization. J Biol Environ Sci 2018;12:69-77.
53. Özdemir K, Demirkan ES. Ethyl methanesulfonate (EMS) mutation for hyper protease production by Bacillus subtilisE6-5 and optimization of culture conditions. Hacettepe J Biol Chem 2020;48:355-65. [https://doi.org/10.15671/hjbc.697070]
54. Agrawal R, Satlewal A, Verma AK. Development of a β-glucosidase hyperproducing mutant by combined chemical and UV mutagenesis. 3 Biotech 2013;3:381-8. [https://doi.org/10.1007/s13205-012-0095-z]
55. Aljammas HA, Yazji S, Azizieh A. Enhancement of protease production from Rhizomucor miehei by mutagenesis with ethyl methanesulfonate, ultraviolet, and microwaves-a preliminary study. Bioresour Technol Rep 2022;20:101287. [https://doi.org/10.1016/j.biteb.2022.101287]
56. Pan S, Chen G, Wu R, Cao X, Liang Z. Non-sterile submerged fermentation of fibrinolytic enzyme by marine Bacillus subtilisharboring antibacterial activity with starvation strategy. Front Microbiol 2019;10:1025. [https://doi.org/10.3389/fmicb.2019.01025]
57. Liu X, Kopparapu NK, Li Y, Deng Y, Zheng X. Biochemical characterization of a novel fibrinolytic enzyme from Cordyceps militaris. Int J Biol Macromol 2017;94:793-801. [https://doi.org/10.1016/j.ijbiomac.2016.09.048]
58. Anusree M, Swapna K, Aguilar CN, Sabu A. Optimization of process parameters for the enhanced production of fibrinolytic enzyme by a newly isolated marine bacterium. Bioresour Technol Rep 2020;11:100436. [https://doi.org/10.1016/j.biteb.2020.100436]
59. Mahajan PM, Nayak S, Lele SS. Fibrinolytic enzyme from newly isolated marine bacterium Bacillus subtilisICTF-1:Media optimization, purification and characterization. J Biosci Bioeng 2012;113:307-14. [https://doi.org/10.1016/j.jbiosc.2011.10.023]
60. Al Farraj DA, Kumar TS, Vijayaraghavan P, Elshikh MS, Alkufeidy RM, Alkubaisi NA, et al. Enhanced production, purification and biochemical characterization of therapeutic potential fibrinolytic enzyme from a new Bacillus flexus from marine environment. J King Saud Univ Sci 2020;32:3174-80. [https://doi.org/10.1016/j.jksus.2020.09.004]